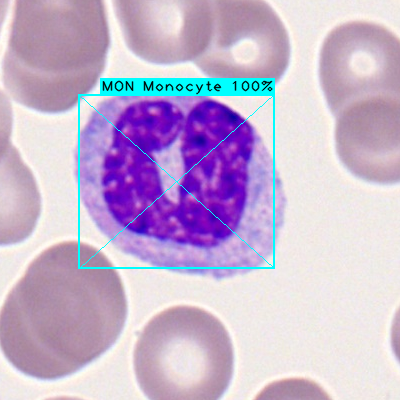
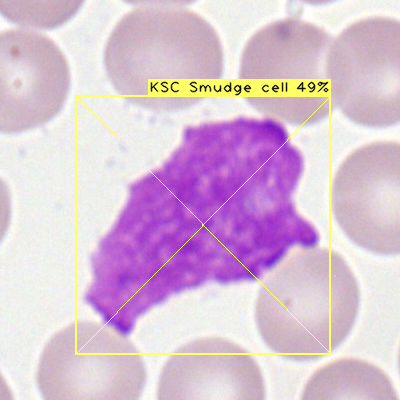
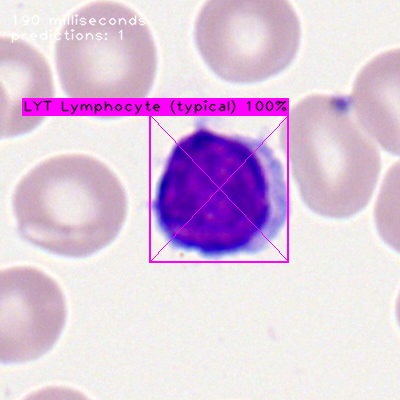
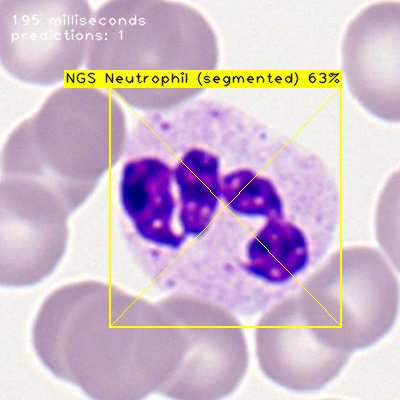
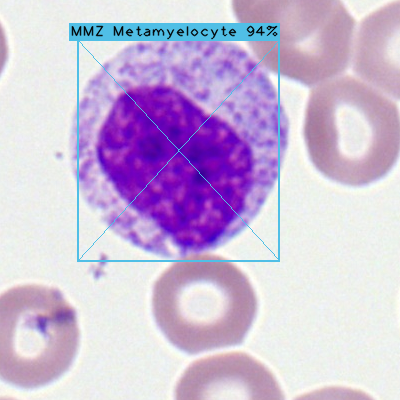
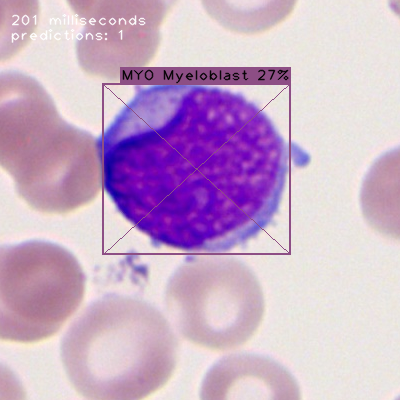
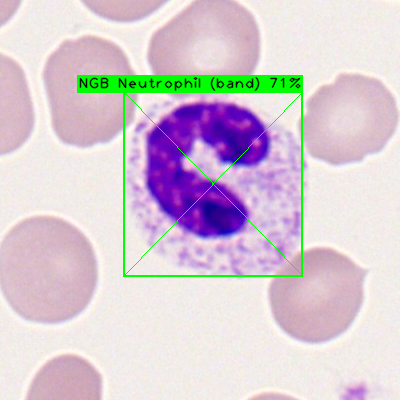

Cancer Cells
Custom artificial neural network trained to recognize 15 different types of cancer cells:
- Basophil
- Eosinophil
- Erythroblast
- Lymphocyte (atypical)
- Lymphocyte (typical)
- Metamyelocyte
- Monoblast
- Monocyte
- Myeloblast
- Myelocyte
- Neutrophil (band)
- Neutrophil (segmented)
- Promyelocyte
- Promyelocyte (bilobled)
- Smudge cell
|
 |
 |
 |
 |
 |
 |
|
 |
 |
 |
|
 |
 |
 |
|
|
 |
 |
|
 |
 |
 |
 |
 |
|
 |
 |
Image source: A Single-cell Morphological Dataset of Leukocytes from TCIA (The Cancer Image Archive).
